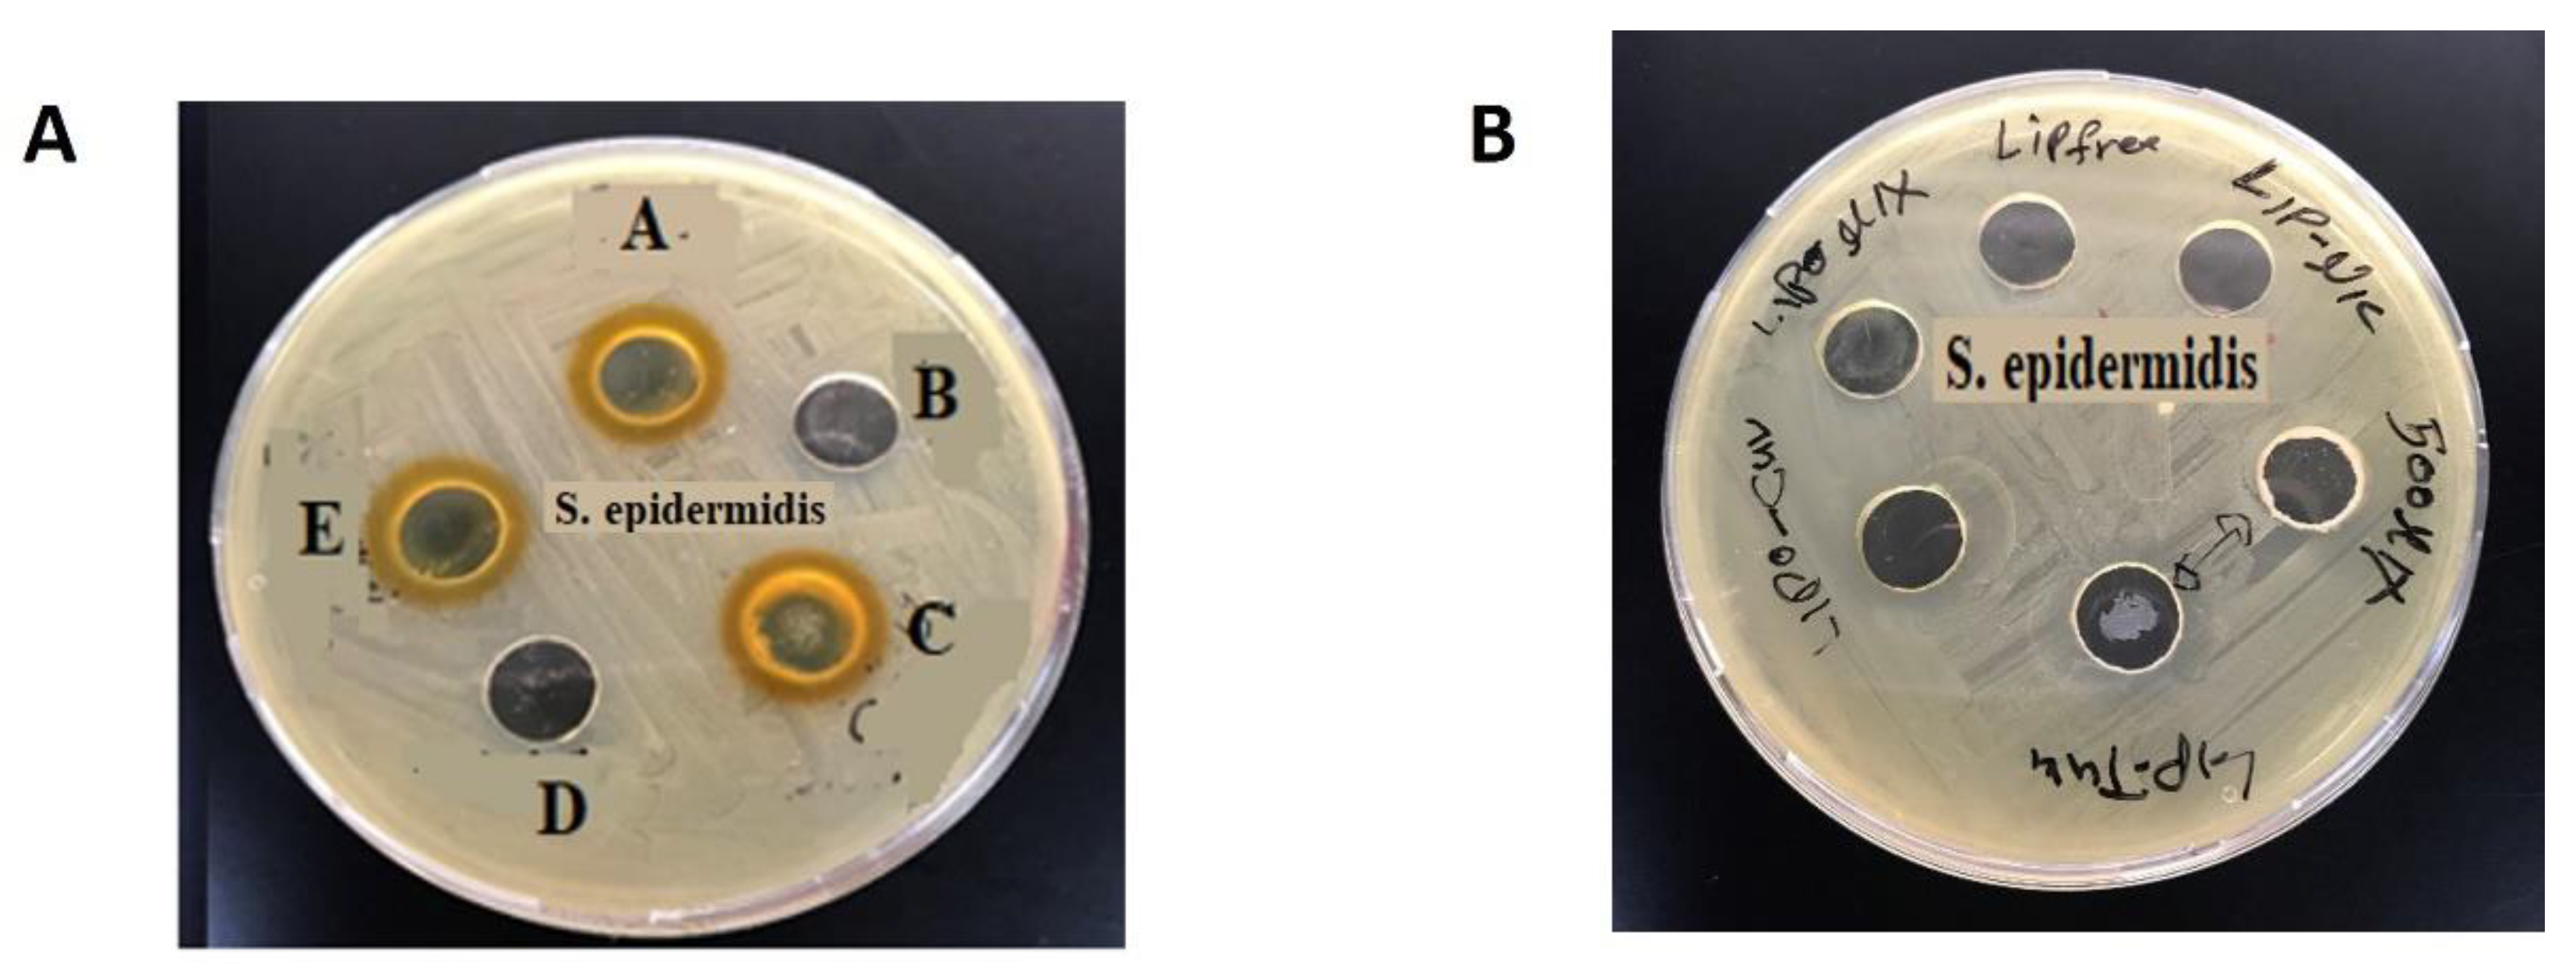
Preprints 142753 g004

Submitted:
12 December 2024
Posted:
13 December 2024
You are already at the latest version
Abstract

Keywords:
1. Introduction
2. Material and Methods
2.1. Liposomal Preparation
2.2. Screening of the Antibacterial Activity
2.2.1. Agar Well-Diffusion Method
2.2.2. Minimum Inhibitory Concentration (MIC)
2.2.3. S. aureus Susceptibility
2.3. Cell Culture
2.3.1. Cell Viability Assay (MTT)
2.3.2. Cell Migration Assay
2.4. DPPH Assay
2.5. Statistical Analysis
3. Results and Discussion
3.1. Liposomal Preparation and Characterization
3.2. Antioxidant Activity and DPPH Assay
3.3. Antibacterial Activity of CUR, NIC and lip- CUR-NC
3.4. Cytotoxicity Study and Anticancer Activity
3.5. Migration Test (Scratch Assay)

4. Conclusions
Author Contributions
References
- Sorrenti V, Burò I, Consoli V, Vanella L. Recent Advances in Health Benefits of Bioactive Compounds from Food Wastes and By-Products: Biochemical Aspects. Int J Mol Sci. 2023;24(3). [CrossRef]
- Nsairat H, Lafi Z, Al-Sulaibi M, Gharaibeh L, Alshaer W. Impact of nanotechnology on the oral delivery of phyto-bioactive compounds. Food Chemistry. 2023;424:136438. [CrossRef]
- Lafi Z, Alshaer W, Ma’mon MH, Zihlif MA, Asha NY, Abdelnabi H, et al. A review Echinomycin: A Journey of Challenges. Jordan Journal of Pharmaceutical Sciences. 2023;16(3):640-54.
- Hammad HM, Imraish A, Al-Hussaini M, Zihlif M, Harb AA, Abu Thiab TM, et al. Ethanol extract of Achillea fragrantissima enhances angiogenesis through stimulation of VEGF production. Endocrine, Metabolic & Immune Disorders-Drug Targets (Formerly Current Drug Targets-Immune, Endocrine & Metabolic Disorders). 2021;21(11):2035-42. [CrossRef]
- Lafi ZM, Irshaid YM, El-Khateeb M, Ajlouni KM, Hyassat D. Association of rs7041 and rs4588 polymorphisms of the vitamin D binding protein and the rs10741657 polymorphism of CYP2R1 with vitamin D status among Jordanian patients. Genetic testing and molecular biomarkers. 2015;19(11):629-36. [CrossRef]
- Matalqah S, Lafi Z, Asha SY. Hyaluronic Acid in Nanopharmaceuticals: An Overview. Current Issues in Molecular Biology. 2024;46(9):10444-61. [CrossRef]
- Watkins RR, Bonomo RA. Overview: Global and Local Impact of Antibiotic Resistance. Infect Dis Clin North Am. 2016;30(2):313-22. [CrossRef]
- Hussain Y, Alam W, Ullah H, Dacrema M, Daglia M, Khan H, et al. Antimicrobial Potential of Curcumin: Therapeutic Potential and Challenges to Clinical Applications. Antibiotics (Basel). 2022;11(3). [CrossRef]
- Chinemerem Nwobodo D, Ugwu MC, Oliseloke Anie C, Al-Ouqaili MTS, Chinedu Ikem J, Victor Chigozie U, et al. Antibiotic resistance: The challenges and some emerging strategies for tackling a global menace. J Clin Lab Anal. 2022;36(9):e24655. [CrossRef]
- Laikova KV, Oberemok VV, Krasnodubets AM, Gal’chinsky NV, Useinov RZ, Novikov IA, et al. Advances in the understanding of skin cancer: ultraviolet radiation, mutations, and antisense oligonucleotides as anticancer drugs. Molecules. 2019;24(8):1516. [CrossRef]
- Abd El-Hack ME, de Oliveira MC, Attia YA, Kamal M, Almohmadi NH, Youssef IM, et al. The efficacy of polyphenols as an antioxidant agent: An updated review. International Journal of Biological Macromolecules. 2023:126525. [CrossRef]
- Munef A, Lafi Z, Shalan N. Investigating anti-cancer activity of dual-loaded liposomes with thymoquinone and vitamin C. Therapeutic Delivery. 2024;15(4):267-78. [CrossRef]
- AlSaleh A, Shahid M, Farid E, Kamal N, Bindayna K. Synergistic antimicrobial effect of ascorbic acid and nicotinamide with rifampicin and vancomycin against SCCmec type IV methicillin-resistant Staphylococcus aureus (MRSA). Access Microbiol. 2023;5(2). [CrossRef]
- Simmons JD, Peterson GJ, Campo M, Lohmiller J, Skerrett SJ, Tunaru S, et al. Nicotinamide Limits Replication of Mycobacterium tuberculosis and Bacille Calmette-Guérin Within Macrophages. J Infect Dis. 2020;221(6):989-99. [CrossRef]
- Murray MF. Nicotinamide: an oral antimicrobial agent with activity against both Mycobacterium tuberculosis and human immunodeficiency virus. Clinical infectious diseases. 2003;36(4):453-60. [CrossRef]
- Starr P. Oral Nicotinamide Prevents Common Skin Cancers in High-Risk Patients, Reduces Costs. Am Health Drug Benefits. 2015;8(Spec Issue):13-4.
- Allen NC, Martin AJ, Snaidr VA, Eggins R, Chong AH, Fernandéz-Peñas P, et al. Nicotinamide for Skin-Cancer Chemoprevention in Transplant Recipients. New England Journal of Medicine. 2023;388(9):804-12. [CrossRef]
- Tosti G, Pepe F, Gnagnarella P, Silvestri F, Gaeta A, Queirolo P, et al. The Role of Nicotinamide as Chemo-Preventive Agent in NMSCs: A Systematic Review and Meta-Analysis. Nutrients. 2024;16(1):100. [CrossRef]
- Surjana D, Halliday GM, Damian DL. Role of nicotinamide in DNA damage, mutagenesis, and DNA repair. Journal of nucleic acids. 2010;2010. [CrossRef]
- Salech F, Ponce DP, Paula-Lima AC, SanMartin CD, Behrens MI. Nicotinamide, a poly [ADP-ribose] polymerase 1 (PARP-1) inhibitor, as an adjunctive therapy for the treatment of Alzheimer’s disease. Frontiers in Aging Neuroscience. 2020;12:255. [CrossRef]
- Lafi Z, Hiba T, Hanan A. An updated assessment on anticancer activity of screened medicinal plants in Jordan: Mini review. Journal of Pharmacognosy and Phytochemistry. 2020;9(5):55-8. [CrossRef]
- Lafi Z, Aboalhaija N, Afifi F. Ethnopharmacological importance of local flora in the traditional medicine of Jordan:(A mini review). Jordan Journal of Pharmaceutical Sciences. 2022;15(1):132-44. [CrossRef]
- Fahdawi A, Shalan N, Lafi Z, Markab O. Analytical Approaches for Assessing Curcumin and Nicotinamide Co-Encapsulated in Liposomal Formulation: UV Spectrophotometry and HPLC Validation. Jordan Journal of Pharmaceutical Sciences. 2024;17(3):468-80. [CrossRef]
- Lafi Z, Alshaer W, Ma’mon MH, Zihlif M, Alqudah DA, Nsairat H, et al. Aptamer-functionalized pH-sensitive liposomes for a selective delivery of echinomycin into cancer cells. RSC Advances. 2021;11(47):29164-77.
- Alshaer W, Zraikat M, Amer A, Nsairat H, Lafi Z, Alqudah DA, et al. Encapsulation of echinomycin in cyclodextrin inclusion complexes into liposomes: in vitro anti-proliferative and anti-invasive activity in glioblastoma. RSC advances. 2019;9(53):30976-88. [CrossRef]
- Allateef A, Shalan N, Lafi Z. Anticancer activity of liposomal formulation co-encapsulated with coumarin and phenyl butyric acid. Journal of Applied Pharmaceutical Science. 2024. [CrossRef]
- Weinstein MP, Lewis JS. The clinical and laboratory standards institute subcommittee on antimicrobial susceptibility testing: background, organization, functions, and processes. Journal of clinical microbiology. 2020;58(3):e01864-19. [CrossRef]
- Grimmig R, Babczyk P, Gillemot P, Schmitz K-P, Schulze M, Tobiasch E. Development and evaluation of a prototype scratch apparatus for wound assays adjustable to different forces and substrates. Applied Sciences. 2019;9(20):4414. [CrossRef]
- Baliyan S, Mukherjee R, Priyadarshini A, Vibhuti A, Gupta A, Pandey RP, et al. Determination of Antioxidants by DPPH Radical Scavenging Activity and Quantitative Phytochemical Analysis of Ficus religiosa. Molecules. 2022;27(4). [CrossRef]
- Allateef A, Shalan N, Lafi Z. Anticancer activity of liposomal formulation co-encapsulated with coumarin and phenyl butyric acid. Journal of Applied Pharmaceutical Science. 2024;14(11):208-15. [CrossRef]
- De Leo V, Milano F, Mancini E, Comparelli R, Giotta L, Nacci A, et al. Encapsulation of Curcumin-Loaded Liposomes for Colonic Drug Delivery in a pH-Responsive Polymer Cluster Using a pH-Driven and Organic Solvent-Free Process. Molecules. 2018;23(4). [CrossRef]
- Zhang Q, Li J, Zhong H, Xu Y. The mechanism of nicotinamide on reducing acute lung injury by inhibiting MAPK and NF-κB signal pathway. Mol Med. 2021;27(1):115. [CrossRef]
- De Leo V, Milano F, Mancini E, Comparelli R, Giotta L, Nacci A, et al. Encapsulation of curcumin-loaded liposomes for colonic drug delivery in a pH-responsive polymer cluster using a pH-driven and organic solvent-free process. Molecules. 2018;23(4):739. [CrossRef]
- Harush-Frenkel O, Bivas-Benita M, Nassar T, Springer C, Sherman Y, Avital A, et al. A safety and tolerability study of differently-charged nanoparticles for local pulmonary drug delivery. Toxicology and Applied Pharmacology. 2010;246(1):83-90. [CrossRef]
- Shajari M, Rostamizadeh K, Shapouri R, Taghavi L. Eco-friendly curcumin-loaded nanostructured lipid carrier as an efficient antibacterial for hospital wastewater treatment. Environmental Technology & Innovation. 2020;18:100703. [CrossRef]
- Stavri M, Piddock LJ, Gibbons S. Bacterial efflux pump inhibitors from natural sources. J Antimicrob Chemother. 2007;59(6):1247-60. [CrossRef]
- Teow SY, Ali SA. Synergistic antibacterial activity of Curcumin with antibiotics against Staphylococcus aureus. Pak J Pharm Sci. 2015;28(6):2109-14.
- Mun SH, Joung DK, Kim YS, Kang OH, Kim SB, Seo YS, et al. Synergistic antibacterial effect of curcumin against methicillin-resistant Staphylococcus aureus. Phytomedicine. 2013;20(8-9):714-8. [CrossRef]
- Zhou Z, Pan C, Lu Y, Gao Y, Liu W, Yin P, et al. Combination of erythromycin and curcumin alleviates Staphylococcus aureus induced osteomyelitis in rats. Frontiers in cellular and infection microbiology. 2017;7:379. [CrossRef]
- Wang Y, Lu Z, Wu H, Lv F. Study on the antibiotic activity of microcapsule curcumin against foodborne pathogens. Int J Food Microbiol. 2009;136(1):71-4. [CrossRef]
- Gunes H, Gulen D, Mutlu R, Gumus A, Tas T, Topkaya AE. Antibacterial effects of curcumin: An in vitro minimum inhibitory concentration study. Toxicol Ind Health. 2016;32(2):246-50.
- Shailendiran D, Pawar N, Chanchal A, Pandey RP, Bohidar HB, Verma AK, editors. Characterization and Antimicrobial Activity of Nanocurcumin and Curcumin. 2011 International Conference on Nanoscience, Technology and Societal Implications; 2011 8-10 Dec. 2011.
- Hu P, Huang P, Chen MW. Curcumin reduces Streptococcus mutans biofilm formation by inhibiting sortase A activity. Arch Oral Biol. 2013;58(10):1343-8. [CrossRef]
- Izui S, Sekine S, Maeda K, Kuboniwa M, Takada A, Amano A, et al. Antibacterial Activity of Curcumin Against Periodontopathic Bacteria. J Periodontol. 2016;87(1):83-90. [CrossRef]

Disclaimer/Publisher’s Note: The statements, opinions and data contained in all publications are solely those of the individual author(s) and contributor(s) and not of MDPI and/or the editor(s). MDPI and/or the editor(s) disclaim responsibility for any injury to people or property resulting from any ideas, methods, instructions or products referred to in the content. |
© 2024 by the authors. Licensee MDPI, Basel, Switzerland. This article is an open access article distributed under the terms and conditions of the Creative Commons Attribution (CC BY) license (http://creativecommons.org/licenses/by/4.0/).
